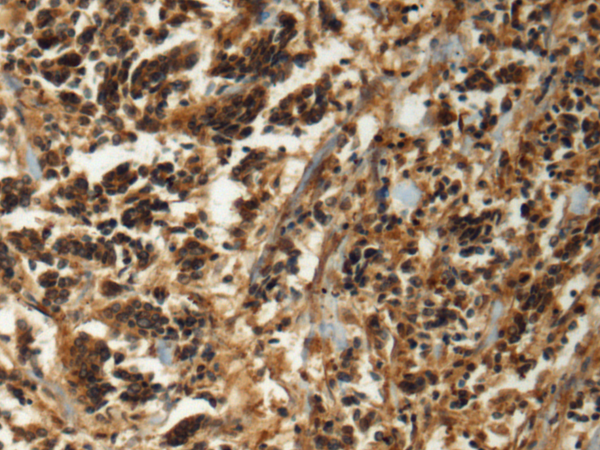

|
Background: |
This gene encodes a member of the cytoskeletal BTB/kelch (Broad-Complex, Tramtrack and Bric a brac) repeat family. The encoded protein plays a role in neurofilament architecture and is involved in mediating the ubiquitination and degradation of some proteins. Defects in this gene are a cause of giant axonal neuropathy (GAN). [provided by RefSeq, Oct 2008] |
|
Applications: |
ELISA, IHC |
|
Name of antibody: |
GAN |
|
Immunogen: |
Fusion protein of human GAN |
|
Full name: |
gigaxonin |
|
Synonyms: |
GAN1; KLHL16 |
|
SwissProt: |
Q9H2C0 |
|
ELISA Recommended dilution: |
5000-10000 |
|
IHC positive control: |
Human breast cancer |
|
IHC Recommend dilution: |
150-300 |
購(gòu)物車(chē)
幫助
021-54845833/15800441009
